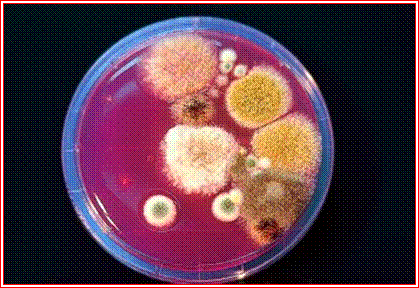

top of page
ACTUALIZACIÓN DE CUIDADOS EN EL PACIENTE CRÍTICO NEUROTRAUMATOLÓGICO
SEGURIDAD CLÍNICA
La seguridad de los pacientes es una dimensión de calidad de la atención sanitaria .Es un tema que preocupa desde hace mucho tiempo, sin
embargo en la última década, diversos estudios realizados han revelado el gran impacto en la morbimortalidad de los eventos adversos. Estos resultados, sumados a la creciente participación de los ciudadanos, han posicionado el tema de la seguridad de los pacientes en un lugar prioritario de la política
sanitaria.

UNIDAD DE CUIDADOS INTENSIVOS HRT
ROSARIO URBÁN CARMONA.SUPERVISORA DE CUIDADOS DE ENFERMERIA
NOELIA ANAYA CARRIÓN .COORDINADORA DE CUIDADOS DE ENFERMERIA
bottom of page